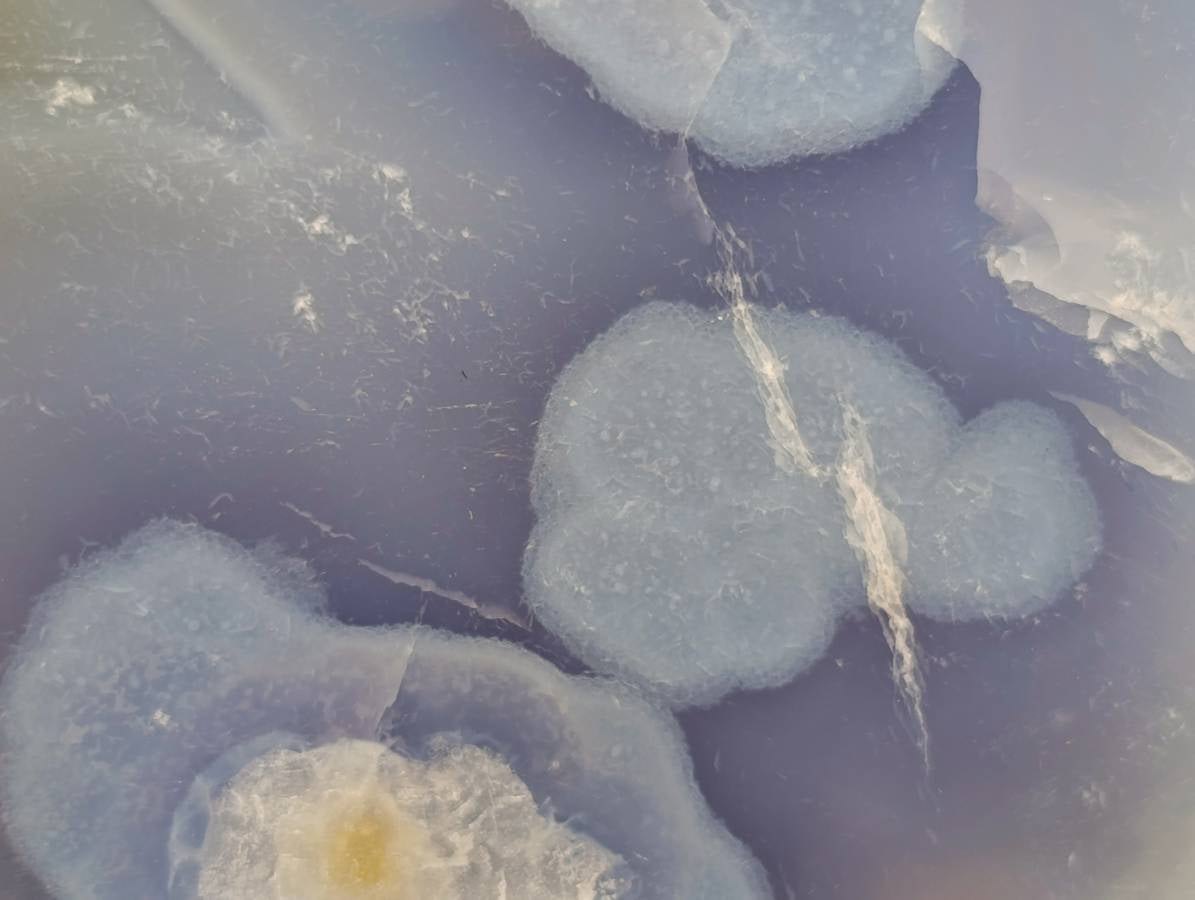
Polished Large Blue Lace Agate Standing Free Form x 1 From Nsanje, Malawi

Polished Large Blue Lace Agate Standing Free Form x 1 From Nsanje, Malawi
A NOTE FROM NICK
A Single Large Blue, White and Smokey, Blue Lace Agate Solid Standing Display Piece. This size is rare with Blue Agate and this one has Neat Blue and White Orbs and Island Patterns. 17.5cm Tall and 4,38 kg in weight, it is a substantial piece.
PRODUCT DESCRIPTION
Blue Lace Agate: Exquisite Geodes, Vugs from Malawi
Blue Lace Agate from Nsanje, Malawi is a beautiful sought after variety of Chalcedony, celebrated for its light blue hues and intricate banding patterns. Characterized by soft, flowing lines and wavy designs, this stone has a delicate and serene appearance.
PRODUCT FEATURES
Hexagonal, Crystalline, Vugs/Cavities, Drusy, Banded
PRODUCT COLOUR
Blue, White
MOHS HARDNESS SCALE
6.5 - 7
PRODUCT DATA
Locality = Nsanje, Malawi
Grade = A Grade
Size = 175 x 183 x 88 mm